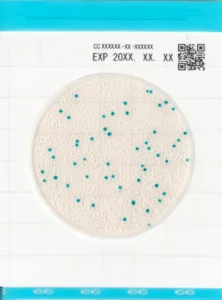
Easy-Plate-CC-Coliform

Easy-Plate-hazir-besiyerleri
Easy Plate Hazır Besiyerleri, genel olarak, mikrobiyolojik testlerinizi çok kolay ve pratik şekilde yapmanızı sağlar. Hazırlık ve sterilizasyon gerektirmez. Kullanıma hazır, inaktif ve hızlı mikrobiyolojik besiyeridir. Güvenilir sonuçlar, uzun raf ömrü, kullanım kolaylığı, zaman, iş gücü ve ekipman tasarrufu sağlar. Geleneksel yöntemlere, güçlü bir alternatiftir. AOAC, NORDVAL VE MİCROVAL sertifikalarına sahiptir. Plakanın etrafında, benzersiz hidrofobik halka, bilhassa, mevcuttur. Bu sayede, numune yayma aparatı, gerekmez. Sonuç itibariyle, plakanın tüm yüzeyine, eşit olarak, kendiliğinden, bütünüyle yayılır.
Standart bir petri kabının yaklaşık 1/20 hacmine sahip olan Easy Plate, inkübatör ve depo alanından büyük ölçüde tasarruf ettirir. Mevcut kapasitenizle çok daha fazla test yapmanızı mümkün kılar. Easy Plate, tüm hazır besiyerlerinden farklı olarak koloni gelişimini çok net ve kontrast bir şekilde gösterdiği için sonuçlar çıplak gözle hızla yorumlanabilir; sayım süreci ekstra bir zorluk olmaktan çıkar. Gözle kolay okunan koloni morfolojisi, sayım hızını yukarı taşır, hata riskini azaltır.
Easy Plate AC, aerobik bakterilerin sayımı için AOAC sertifikalı, özel hazırlık ve sterilizasyon gerektirmeyen, hazır steril besiyeridir. Kolayca ayırt edilebilen, renkli kırmızı koloniler sağlayan bir kimyasal indikatör içerir. Aerobik bakterileri 48 saat içinde kolayca tanımlayıp saymanızı sağlar.
Easy-Plate-CC-Coliform
Easy Plate CC, koliformların tespiti, önce tanımlanması ve sonra sayımı için AOAC sertifikalı, özel hazırlık ve sterilizasyon gerektirmeyen, hazır ve steril besiyeridir. Koliformların ayırt edilebilir mavi bir renk almasına neden olan kromojenik bir substrat içerir. Koliformları 24 saat içinde kolayca tanımlayıp saymanızı sağlar.
E. coli ve koliformların tespiti, önce tanımlanması ve sonra sayımı için AOAC sertifikalı özel hazırlık ve sterilizasyon gerektirmeyen, hazır ve steril bir besiyeridir. E.coli mavi, koliformlar ise kırmızı renkte 24 saatte kolayca tanımlayıp saymanızı sağlar. Kolonilerin belirgin renkleri, gıda ve su testlerinde sık karşılaşılan etkileşimlerin üstesinden gelmeye yardımcı olarak E. coli ve koliformların test edilmesini ve sayımını kolaylaştırır.
Easy Plate SA, Staphylococcus aureus tespiti, önce tanımlanması ve sonra sayımı için, AOAC sertifikalı özel hazırlık ve sterilizasyon gerektirmeyen, hazır, steril besiyeridir. Kolayca ayırt edilebilen parlak renkli mavi koloniler üreten kromojenik bir substrat içerir. İnkübasyon süresi 24±1 saate düşer. Ekstra bir doğrulama veya tanımlama adımına ihtiyaç duyulmaz.
EASY-PLATE-YMR-Yeast-Mould-Rapid
Easy Plate YM-R, maya ve küf tespiti, önce tanımlanması ve sonra sayımı için, AOAC sertifikalı özel hazırlık ve sterilizasyon gerektirmeyen, hazır, steril besiyeridir. Easy Plate YM-R , 5 günlük inkübasyon süresini 48 saate indirir. Kimyasal indikatör mor koloniler oluşturarak, gıda kalıntılarının varlığında bile kolonileri tanımlamayı ve saymayı kolaylaştırır. Küf kolonileri geniş bir alana yayılıp, dağınık kenarlı mor koloniler oluşturur. Maya kolonileri küçük daireler oluşturup, belirgin kenarlara sahiptir. Bununla birlikte, renklendirme özelliği sayesinde temiz ve ayırt edilebilmesi son derece kolay bir görüntü sağlar.
Easy Plate EB, Enterobacteriaceae, tespiti, önce tanımlanması ve sonra sayımı için, AOAC sertifikalı özel hazırlık ve sterilizasyon gerektirmeyen, hazır, steril besiyeridir. VRBG besiyeri ve koloni sayımını kolaylaştıran soğuk suda çözünür bir jelleştirici içeren bir mikrobiyal test kitidir. Koloniler 24 saat içinde kolayca tespit edilir.
Easy Plate gözle hızla ve sorunsuz yorumlanabilir. Aynı zamanda, özel tarayıcı cihaz ve görüntü analiz yazılımıyla, sayım süreci, baştan sona, tamamen dijitalleşir. Bununla birlikte, operatöre bağlı kalmaksızın, standart, bilhassa, denetime hazır sonuçlar verir. Bununla birlikte, tüm ayrıntılarıyla erişimi kolay bir arşiv sağlar. Ek olarak, yazılım ücretsiz olarak indirilebilir.
Tarayıcı, Easy Plate’de üremiş olan kolonileri, baştan sona, tamamıyla, otomatik olarak sayar. Sonrasında, analiz eder. Manuel sayımdan daha basit ve zaman kazandıran bu yöntem, verimliliği artırır. Üstelik, operatörler arasındaki değişkenlik ve beceri seviyesi etkilerini, tümüyle ortadan kaldırır.
Easy Plate görüntüleme amacıyla, “BROTHER INDUSTRIES” tarafından üretilen, ADS-4300N tarayıcı, özellikle, gereklidir. Bu sebeple, tarayıcı cihazı tedarik amacıyla, firmamızla iletişime geçebilirsiniz.
https://biochemifa.kikkoman.com/e/kit/product/easy-plate/ccs/
https://skalateknik.com/kikkoman-lumitester-smart-hijyen-monitoru/
JAPON KiKKOMAN üRETiCi FiRMA LiNKi:
https://biochemifa.kikkoman.com/e/kit/product/easy-plate/
Skala Teknik
Typically replies within minutes
Any questions related to EASY PLATE HAZIR BESiYERi – STERiL – DEHiDRE – KROMOJENiK – KULLANIMA HAZIR BESiYERLERi?
WhatsApp Us
🟢 Online | Privacy policy

